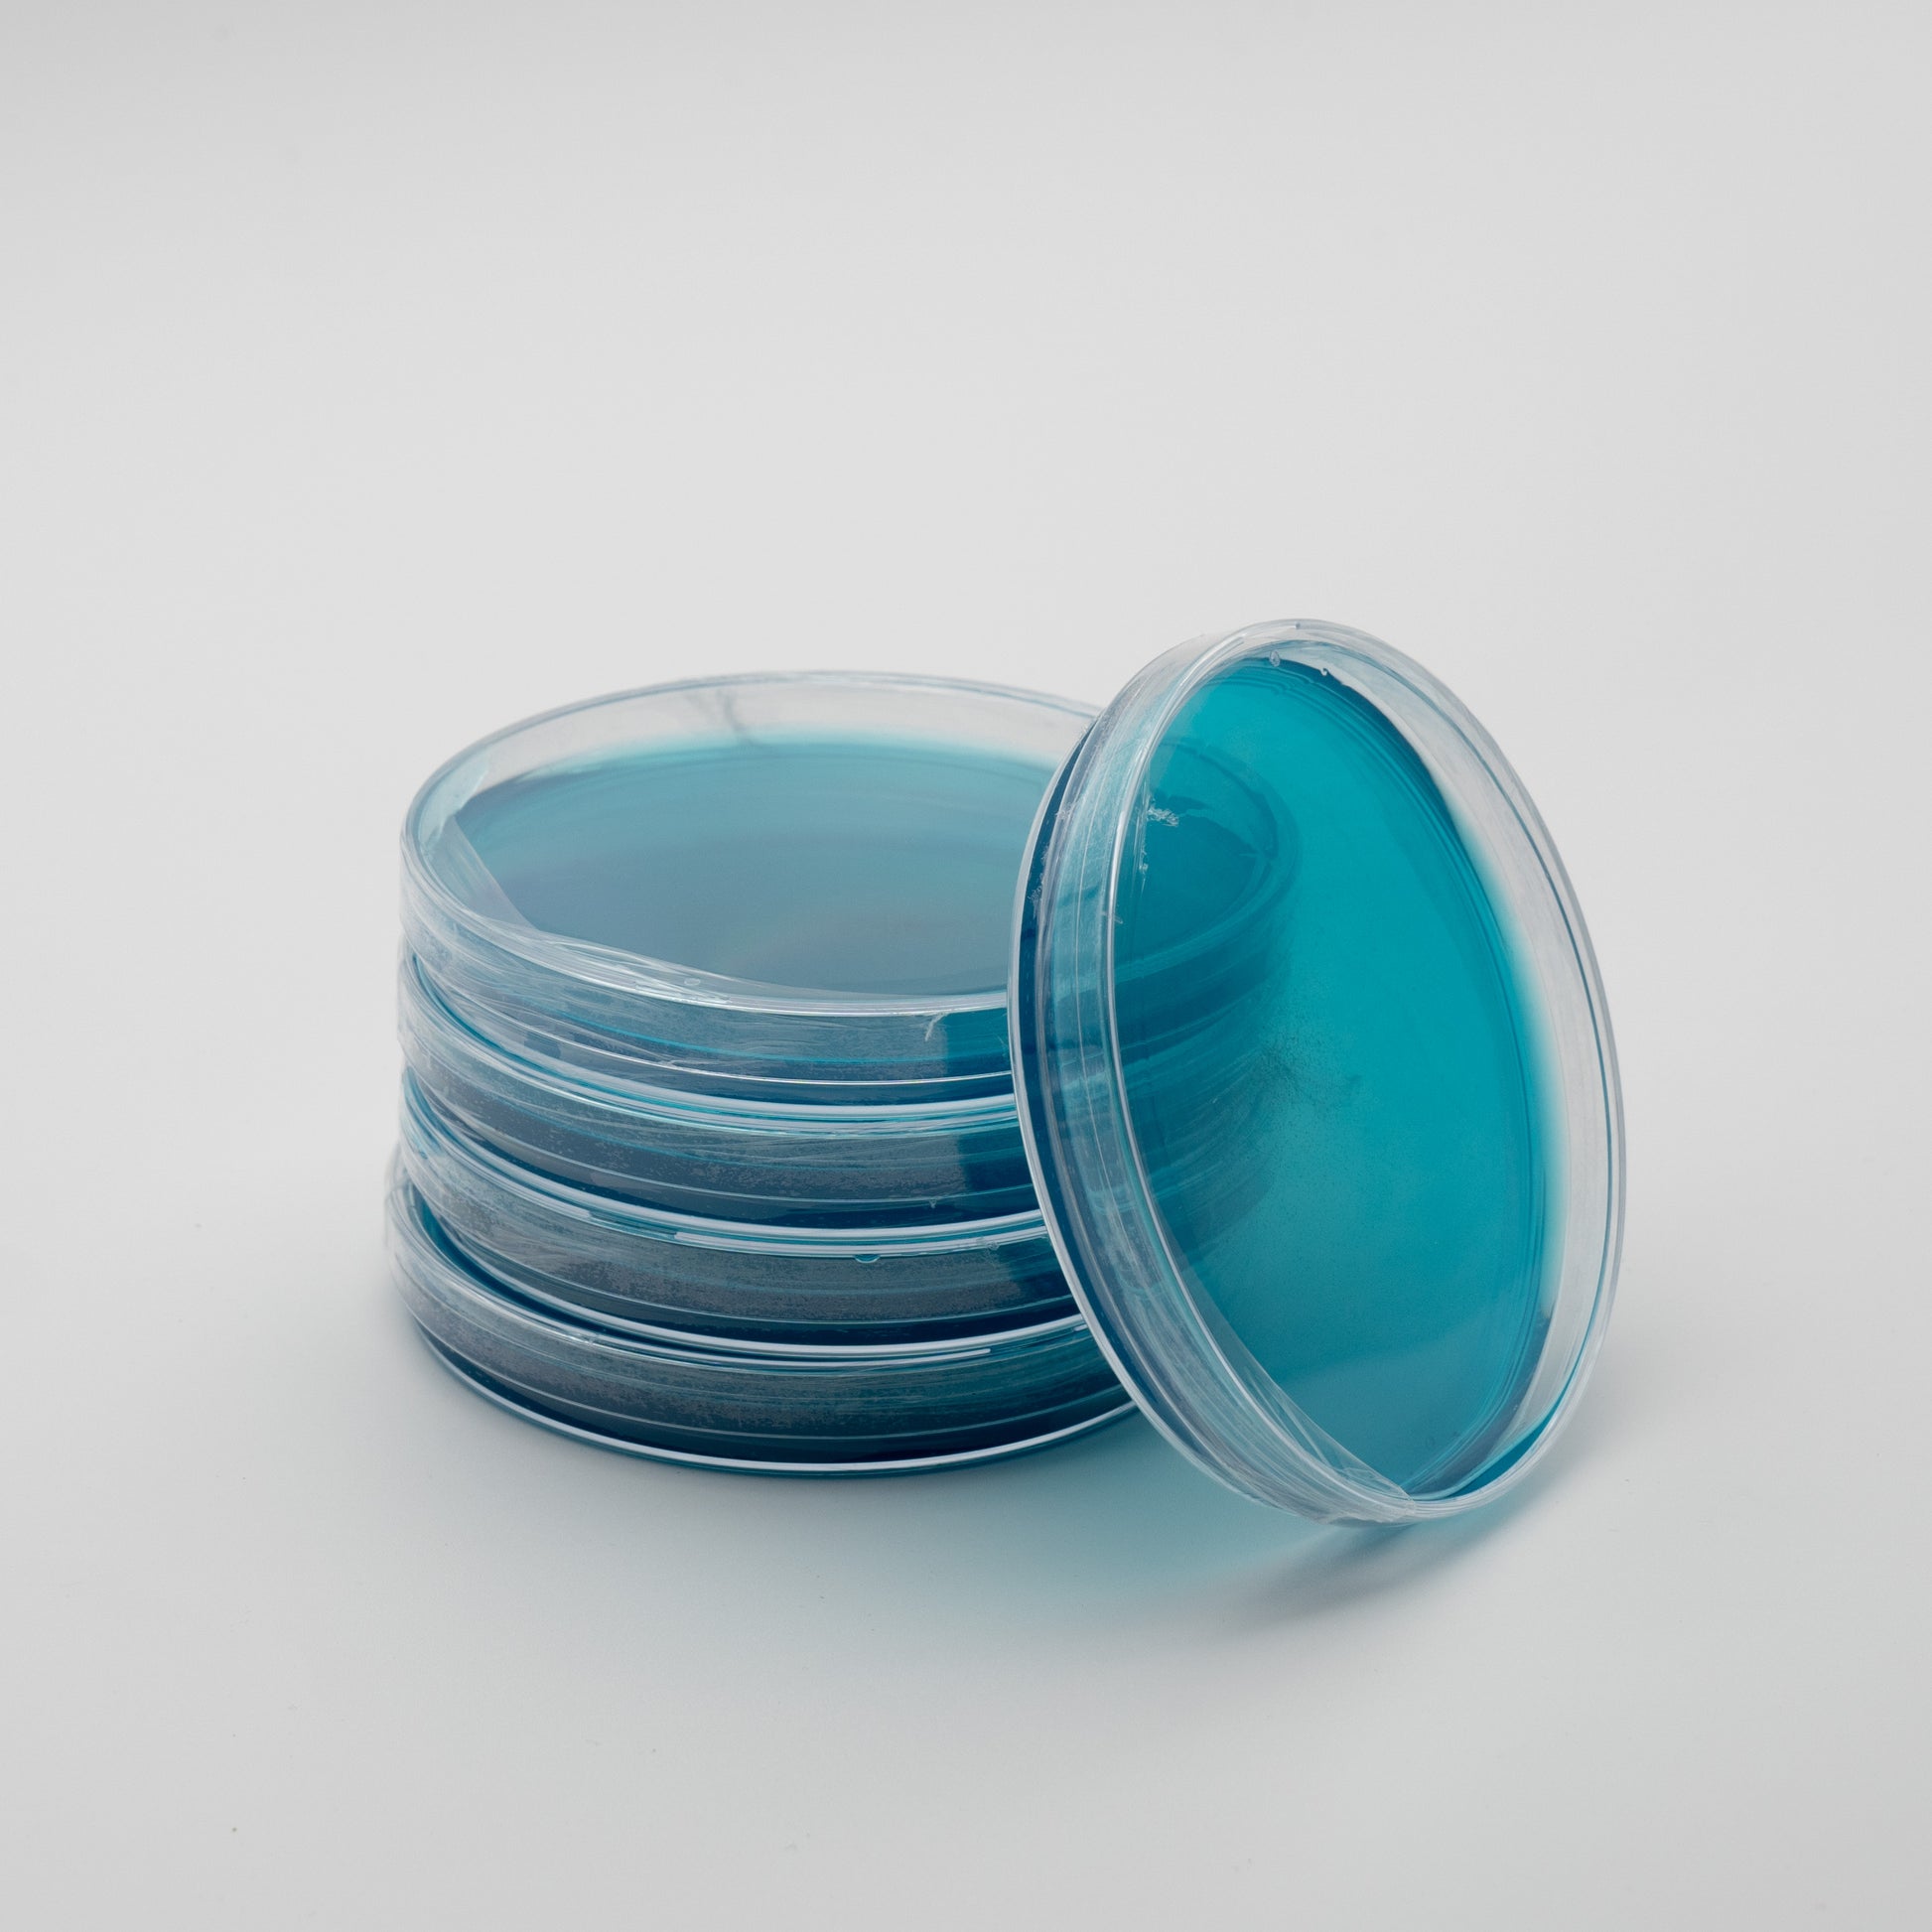

Agar Dishes - Light Malt Extract (LME) For Mushroom Growing
Agar Dishes - Light Malt Extract (LME) For Mushroom Growing
Couldn't load pickup availability
These 10 LME (Light Malt Extract) agar plates are a versatile and essential tool for mycology enthusiasts and researchers. Available in a variety of colours, these agar plates are perfect for differentiating between various strains of fungi and making the identification process easier. The LME agar medium is a nutrient-rich mixture that provides an optimal growing environment for fungal cultures. The plates are carefully prepared under sterile conditions to prevent contamination and ensure consistent results. These agar plates can be used for a range of mycological applications such as mushroom cultivation, spore germination, and fungal isolation. Whether you're a beginner or an experienced mycologist, these LME agar plates are a great addition to your collection and will help you study the fascinating world of fungi.
Shipping & Returns
Shipping & Returns
Delivery time 2-4 Days.
Please note that some items are made in batches which can result in a longer overall time for arrival.
if for any reason you receive a product that does not meet your expectations, please contact us within 14 days of receiving your order to request a refund.
Collection Available.